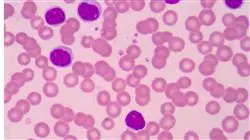
##IMAGE##

Titulación universitaria
La mayor facultad de medicina del mundo”
Presentación del programa
Conviértete en un experto en Estrategias de Abordaje en MI en solo 6 semanas”

Las diferentes Estrategias de Abordaje son factores esenciales en la Medicina Integrativa, que se nutre de las últimas técnicas en medicina complementaria y de los más recientes avances en medicina convencional. El tratamiento integral de todo el conjunto de sistemas que componen al individuo puede llevarse a cabo a través de diferentes métodos en función de la enfermedad, pero requiere de unos conocimientos amplios y específicos.
Este es el motivo por el que TECH ha diseñado un Curso Universitario en Estrategias de Abordaje en Medicina Integrativa, para potenciar los perfiles profesionales de los alumnos en su capacidad para llevar a cabo su labor con la máxima eficiencia y calidad posibles. Y esto, a través del ahondamiento en aspectos como el Modelo Biológico, la Autoinmunidad, los Aspectos Antropológicos y Filosóficos o la Reflexología Podal.
La participación de una directora invitada internacional de renombre en el Curso Universitario es un testimonio del compromiso constante con la excelencia académica. A través de sus Master Classes, los estudiantes profundizarán en las principales Estrategias de Abordaje en Medicina Integrativa.
Todo ello, a través de una modalidad 100% online que permite al alumno organizar su actividad con total libertad, sin ver interferidas sus otras obligaciones por la superación de este programa. Además, con la total disposición de los materiales multimedia más completos y la información más actualizada del mercado académico.
Descubre las novedades más relevantes en Estrategias de Abordaje en Medicina Integrativa con la perspectiva internacional de una directora invitada de renombre”
Este Curso Universitario en Estrategias de Abordaje en Medicina Integrativa contiene el programa científico más completo y actualizado del mercado. Sus características más destacadas son:
- El desarrollo de casos prácticos por expertos en Estrategias de Abordaje en Medicina Integrativa
- Los contenidos gráficos, esquemáticos y eminentemente prácticos con los que está concebido recogen una información científica y práctica sobre aquellas disciplinas indispensables para el ejercicio profesional
- Los ejercicios prácticos donde realizar el proceso de autoevaluación para mejorar el aprendizaje
- Su especial hincapié en metodologías innovadoras
- Las lecciones teóricas, preguntas al experto, foros de discusión de temas controvertidos y trabajos de reflexión individual
- La disponibilidad de acceso a los contenidos desde cualquier dispositivo fijo o portátil con conexión a internet
Adquiere nuevos conocimientos de forma ágil y precisa, gracias al contenido más completo en Cineantropometría y Reflexología Podal”
El programa incluye en su cuadro docente a profesionales del sector que vierten en esta capacitación la experiencia de su trabajo, además de reconocidos especialistas de sociedades de referencia y universidades de prestigio.
Su contenido multimedia, elaborado con la última tecnología educativa, permitirá al profesional un aprendizaje situado y contextual, es decir, un entorno simulado que proporcionará una capacitación inmersiva programada para entrenarse ante situaciones reales.
El diseño de este programa se centra en el Aprendizaje Basado en Problemas, mediante el cual el profesional deberá tratar de resolver las distintas situaciones de práctica profesional que se le planteen a lo largo del curso académico. Para ello, contará con la ayuda de un novedoso sistema de vídeo interactivo realizado por reconocidos expertos.
Ahonda en las diferentes Estrategias de Abordaje de forma rápida y sin moverte de casa”

Dispondrás de la biblioteca de recursos multimedia durante las 24 horas del día, pudiendo acceder desde tu móvil, Tablet u ordenador"
Plan de estudios
La estructura y el contenido de este Curso Universitario en Estrategias de Abordaje en Medicina Integrativa han sido diseñados por los docentes expertos en la materia que forman parte de TECH y que han volcado sus conocimientos y su experiencia en todos los materiales, para garantizar la mejor asimilación posible de los diferentes conceptos. Además, se han basado en la metodología pedagógica más eficiente, el Relearning.

Adquiere nuevas habilidades en MI de forma natural y progresiva, gracias al Relearning, la metodología pedagógica más eficiente del mercado”
Módulo 1. Enfoques y Estrategias de Abordaje
1.1. Modelo Biológico
1.1.1. Interrelación de los Sistemas Fisiológicos
1.1.2. Fisiología y disfunción mitocondrial
1.1.3. Inflamación crónica y síndromes de permeabilidad de mucosas
1.1.4. Implicación de los trastornos del sistema inmune en las patologías crónicas
1.1.4.1. Autoinmunidad
1.1.5. Papel del Estrés Oxidativo
1.1.6. Microbiota
1.1.7. Fisiología de la detoxificación
1.2. Enfoque sistémico
1.2.1. Gestáltico
1.2.2. Transgeneracional
1.3. Enfoque desde el Psicoanálisis
1.4. Cosmogonía de la Medicina Oriental
1.4.1. Aspectos Antropológicos y Filosóficos
1.4.1.1. Cineantropometría y relación con cadenas cinéticas
1.4.2. Los puntos en la acupuntura desde la embriología humana
1.4.3. Bases científicas de la Acupuntura contemporánea
1.4.4. Microsistemas
1.4.4.1. Reflexología Podal
1.4.4.2. Técnica zonal refleja auricular
1.4.4.3. Otras disciplinas ( la acupuntura craneal de Yamamoto YNSA)
1.5. Imago, arquetipo y diátesis constitucionales
Un programa 100% online que te permitirá destacar como profesional de las Estrategias de Abordaje en MI, sin salir de casa”
Curso Universitario en Estrategias de Abordaje en Medicina Integrativa
Gracias a las recientes investigaciones realizadas, los enfoques integrativos para el manejo de diferentes patologías han evolucionado significativamente, obligando al médico a conocerlos para no verse regazado respecto a los avances del sector. Por ello, si estás interesado en actualizarte en esta materia, el Curso Universitario en Estrategias de Abordaje en Medicina Integrativa es tu mejor opción. Profundizarás, durante esta experiencia académica, en el vanguardista enfoque psicoanalítico para tratar las afecciones o en las punteras técnicas de acupuntura. Todo este aprendizaje, sin renunciar a tus obligaciones profesionales y mediante una moderna metodología 100% online.
Actualízate junto a especialistas en Medicina Integrativa
Si tu objetivo es actualizar tus técnicas para el trato con el paciente desde una perspectiva holística de la salud, el Curso Universitario en Estrategias de Abordaje en Medicina Integrativa se ha desarrollado para ti. A través del mismo identificarás los enfoques más modernos para abordar numerosas patologías mediante recursos naturales y alternativos al tratamiento convencional, con el fin de mejorar la calidad de vida del paciente con enfermedades crónicas. ¡Inscríbete y aprende con recursos didácticos en los formatos multimedia más sofisticados!







